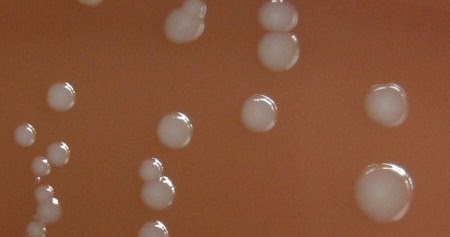

Sustainable Spring Cleaning for Your Koi Pond: Tips, Tricks, and Tools
Introduction
Owning a koi pond is a rewarding experience. However, it’s no secret that keeping one requires a lot of work and maintenance. With spring upon us, it’s time to start thinking about giving your pond a thorough cleaning to get it ready for the upcoming season. In this article, we’ll share some tips, tricks, and tools to help you carry out a sustainable spring cleaning for your koi pond.
Why Choose Sustainable Spring Cleaning?
Traditional cleaning methods for koi ponds involve using harsh chemicals and tools that can harm both the environment and the fish. By choosing sustainable methods, you’re not only reducing your environmental impact, but you’re also creating a healthier environment for your beloved koi.
Tools You’ll Need
Before you get started with your sustainable spring cleaning, it’s important to ensure that you have the necessary tools on hand. Here are some of the most essential tools you’ll need:
1. A Skimmer Net

This net is useful for removing any leaves or debris that have fallen into the pond over the winter. It’s a good idea to do this before draining the pond, as it will make the process smoother.
2. A Pump and Hose

A pump and hose will help you drain the water from the pond. Make sure to choose a pump that’s appropriate for the size of your pond. You will also need a hose that fits the pump and is long enough to reach your desired drainage point.
3. Gloves
Put on some heavy-duty gloves to protect your hands from any sharp objects in and around the pond.
4. A Scrubbing Brush

A scrubbing brush will come in handy when it’s time to remove any algae or debris that’s stuck to the pond’s walls or floor.
5. Beneficial Bacteria
Beneficial bacteria help maintain a healthy environment for your koi. They’re essential for breaking down waste and reducing the growth of harmful bacteria and algae. Look for bacteria that’s specifically formulated for ponds and follow the manufacturer’s instructions for use.
Step-by-Step Guide to Sustainable Spring Cleaning
Now that you have all the necessary tools, let’s dive into the step-by-step guide to sustainable spring cleaning your koi pond.
1. Drain the Water

Use the pump and hose to drain the water from the pond. Direct the water to an appropriate drainage point. If you live in an area with water restrictions, consider using the drained water for your plants or lawn.
2. Remove Debris

With the skimmer net, remove any leaves, twigs, or other debris that’s accumulated in the pond. This will make it easier to clean the pond’s walls and floor later on.
3. Clean the Pond

Put on your gloves and use the scrubbing brush to clean the pond’s walls and floor. Be sure to rinse the brush regularly to remove any debris. If you encounter stubborn algae or debris, consider using a natural cleaning solution, such as vinegar or baking soda. Once you’ve finished scrubbing, rinse the pond thoroughly with a hose.
4. Add Beneficial Bacteria

Now that the pond is clean, it’s time to add beneficial bacteria. Follow the manufacturer’s instructions for use and be sure to spread the bacteria evenly throughout the pond. Leave the bacteria to work its magic for 24 to 48 hours before adding water.
5. Refill the Pond

With the pond cleaned and bacteria added, it’s time to refill it with water. Make sure to use dechlorinated water, as chlorine can be harmful to your koi. Slowly fill the pond to avoid disturbing the substrate or your koi.
Conclusion
With these tips, tricks, and tools, you’re well-equipped for a sustainable spring cleaning for your koi pond. By choosing sustainable methods, you’re not only doing your part for the environment, but you’re also creating a healthier and happier environment for your koi. Happy cleaning!